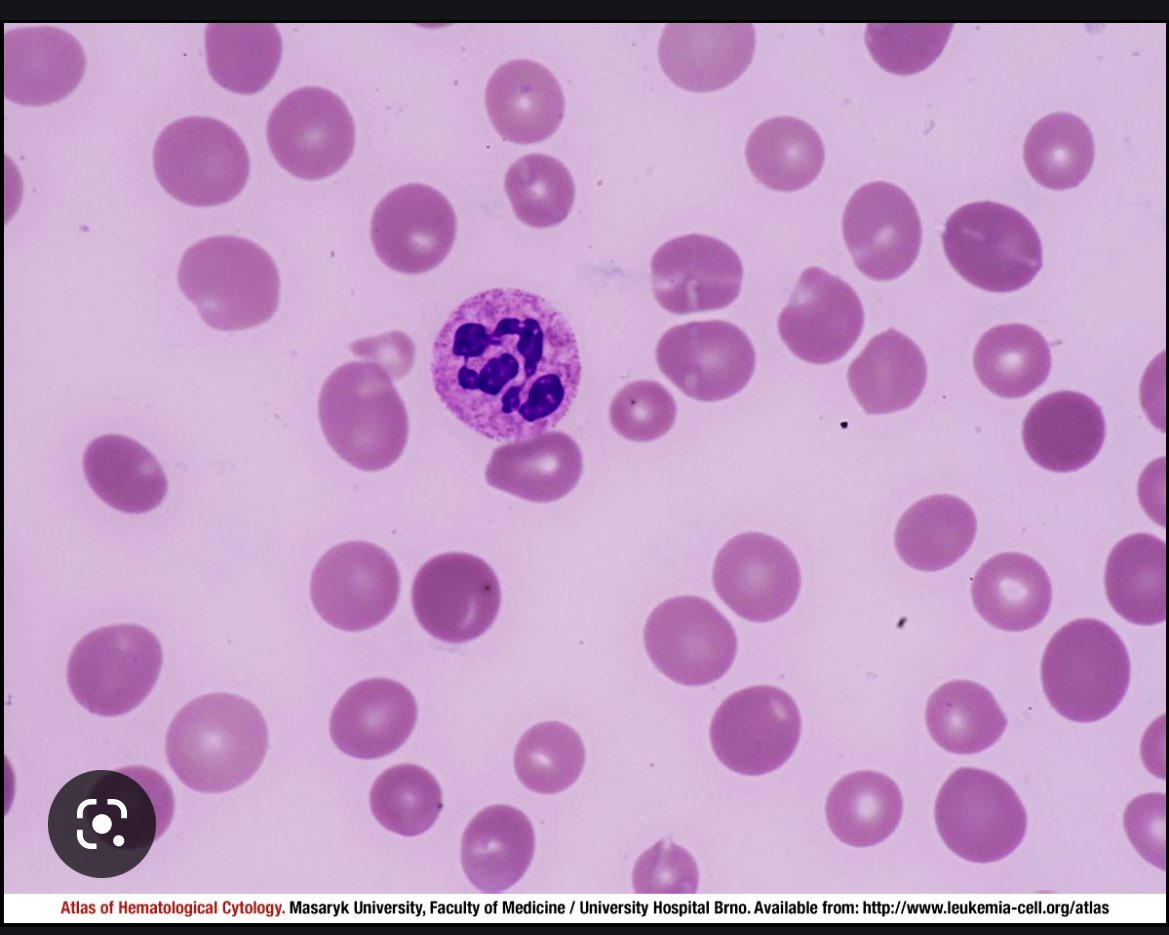
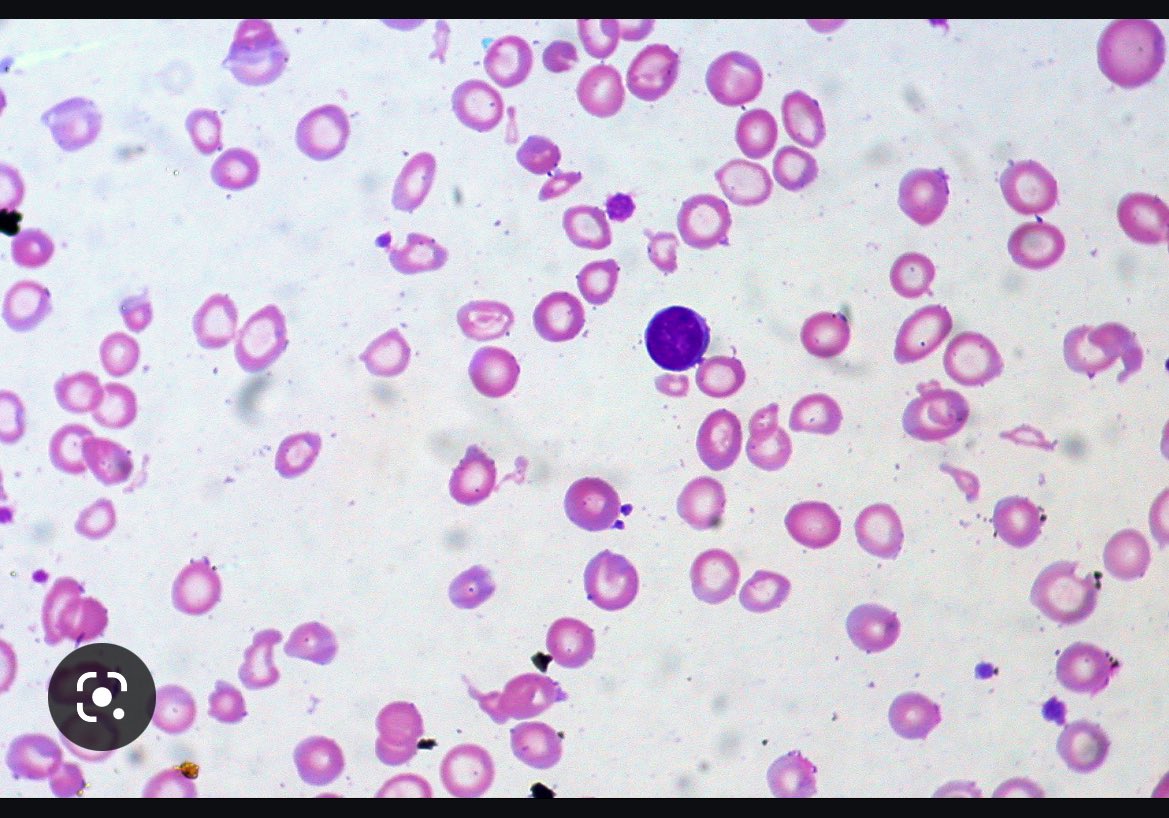

الثريد الرابع والأخير لقسم Hematology وبدايه لقسم الزواج الصحي🤩✨
.
.
#تسائل_متدرب
كيف يتم الكشف عن الثلاسيما والأنيميا المنجلية وأنيما الفول وهل يتم الطلب عليها في غير قسم الدم؟
سوف نتعرف على ذلك
.
.
قراءة ممتعه🤝
.
.
#تسائل_متدرب
كيف يتم الكشف عن الثلاسيما والأنيميا المنجلية وأنيما الفول وهل يتم الطلب عليها في غير قسم الدم؟
سوف نتعرف على ذلك
.
.
قراءة ممتعه🤝
في حين الأنواع الأخرى ك الانيميا المنجليه والثلاسيما والفول فقد اثبتت الدراسات بأن العامل الاساسي بظهورها هو العامل الوراثي لذلك يجب عمل التحليل للمقبلين على الزواج لمنع هذي الانواع من ظهورها على الأطفال فهي تشكل تحديًا وتهديدًا على حياة المريض عند إصابته بها.
فماهي التقنيه المستخدمه للكشف عنها؟
في بادئ الأمر وهي قاعدة أساسيه لتحاليل عينات قسم علم الدم يتم عمل CBC فهي تعمل على فك الشفرات وتسهيل الوصول للتشخيص في أحيانٍ كثيره وهذا لايمنع
بعمل تحاليل أخرى بعدها للمساعده أيضًا.
في بادئ الأمر وهي قاعدة أساسيه لتحاليل عينات قسم علم الدم يتم عمل CBC فهي تعمل على فك الشفرات وتسهيل الوصول للتشخيص في أحيانٍ كثيره وهذا لايمنع
بعمل تحاليل أخرى بعدها للمساعده أيضًا.
فإن كان الشخص مصاب بالمنجليه سيتم النظر اليهم جميعًا فإن أظهر HgbS وكان المعدل اكثر من70%فإنها دلاله على الاصابه في حين كانت اقل ستدل على ان الشخص حامل للمرض
اما الثلاسيميا ان اظهرت HgbA2 اعلى من 3.5%سيتم النظر في A0 ان اظهرت اقل من 60% دلاله على انه مصاب وان كان اكثر دلاله على انه حامل للمرض.

cdc.gov/ncbddd/thalass…
What is Thalassemia? | CDC
Thalassemia is an inherited (i.e., passed from parents to children through genes) blood disorder.
hopkinsmedicine.org/health/conditi…
Vitamin B12 Deficiency Anemia
Vitamin B12 deficiency anemia is a condition in which your body does not have enough healthy red blo...

mayoclinic.org/diseases-condi…
Anemia - Symptoms and causes
Having too few healthy red blood cells causes tiredness and weakness. There are many types of this c...
جاري تحميل الاقتراحات...